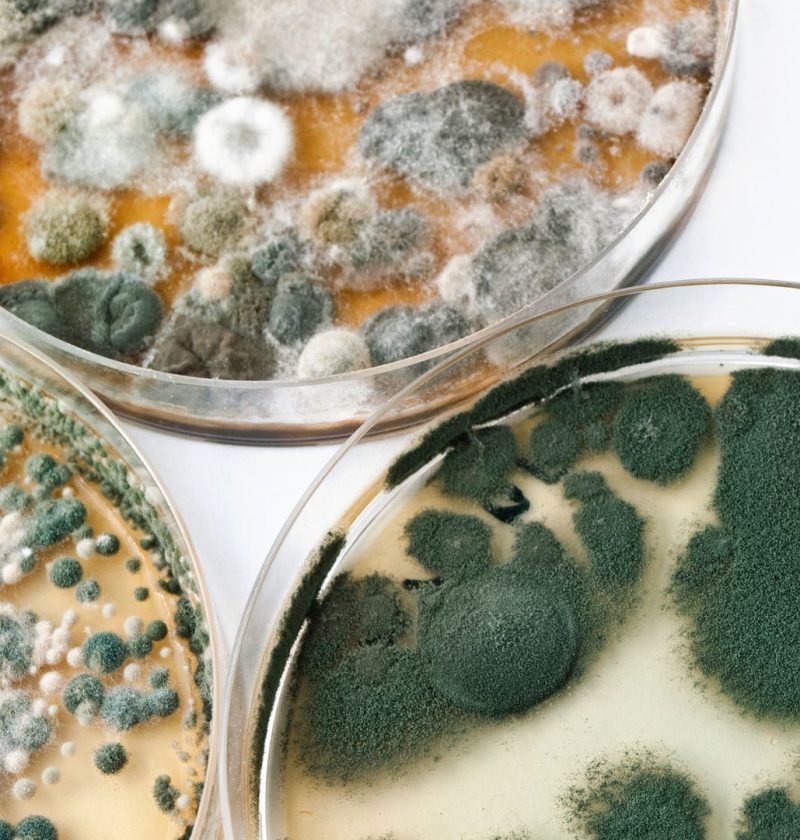

Inonotus obliquus, conocido como hongo chaga, es un hongo medicinal que ha sido utilizado en la medicina tradicional de Rusia, Europa del Este y Asia durante siglos. En los últimos años, ha ganado popularidad en todo el mundo debido a su potencial para mejorar la salud y prevenir enfermedades.
Este artículo profundiza en el cultivo y las propiedades medicinales del hongo chaga, incluyendo su composición química, beneficios para la salud y cómo se puede utilizar como complemento natural para tratar diversas enfermedades. También se examinan las diversas formas en que se puede consumir el hongo chaga, incluyendo cápsulas, polvo, té y extracto líquido.
Además, se aborda la importancia del cultivo sostenible de Inonotus obliquus y las prácticas éticas que deben seguirse para garantizar la calidad y la seguridad del producto final. En general, este artículo ofrece una visión completa del hongo chaga y su potencial para mejorar la salud y el bienestar de las personas en todo el mundo.